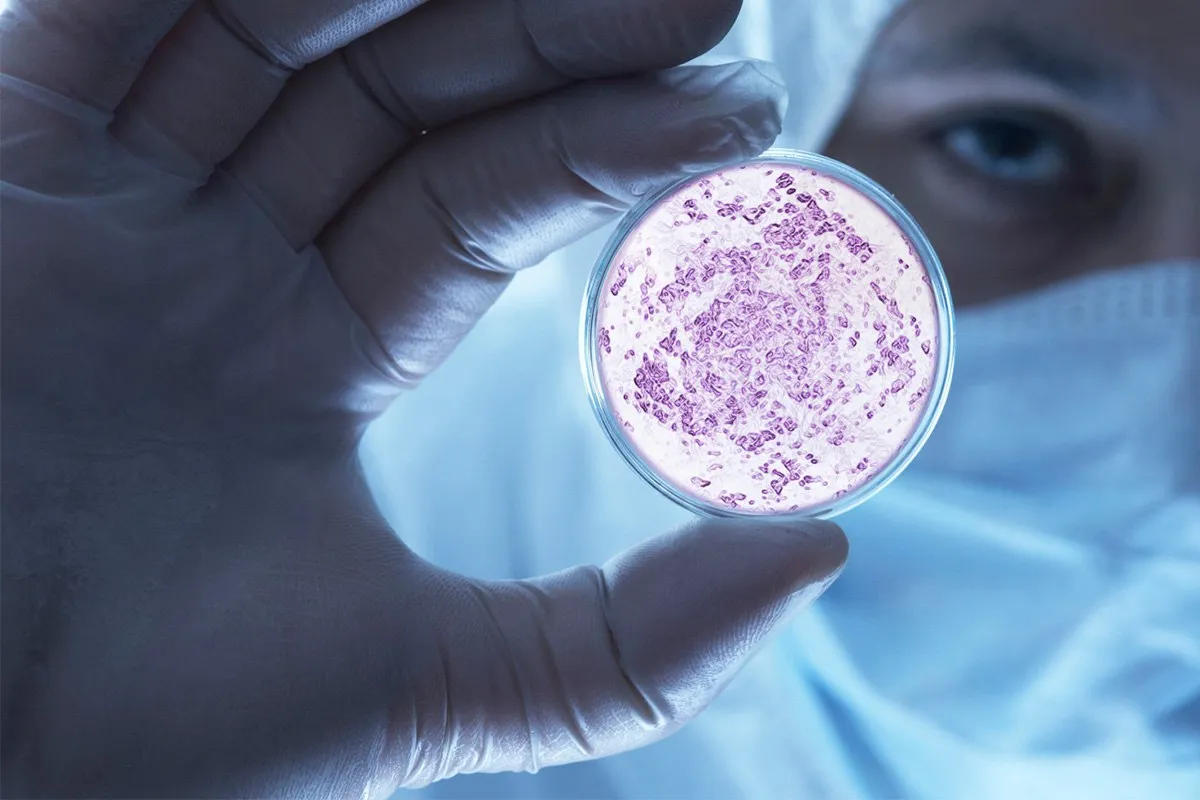
Исследование

Глава турагентства Go Travel Ансталь рассказала о вспышке ротовируса в Турции
- 29 августа 2023 19:41
- Валентина Родионова , журналист «Ридуса»
В соцсетях от россиян, отдыхающих на курортах Турции, появляется информация о вспышке ротовируса на пляжах Средиземного моря. Некоторые утверждают, что проблема приобретает массовый характер. Однако официального подтверждения этому нет.
Глава турагентства Go Travel Наталия Ансталь сообщила, что ничего необычного в ситуации нет, это повторяется каждый год в пик летних отпусков.
«В жаркую погоду бактериям в воде проще размножаться. Если бассейны отеля хлорируют, то море — нет. Возможность подцепить инфекцию есть в любом регионе, где вода [достигает] высоких температур», — пояснила «360» эксперт.
Туристам, которые намерены отправиться на отдых в Белек следует соблюдать обычные меры гигиены после купания в море, а также заранее собрать в путешествие аптечку со всем необходимым.
По ее словам, как правило, медицинская страховка покрывает лечение от ротовируса.
«Нужно позвонить в страховую и сказать, что произошло, какие симптомы. Могут прислать врача из отеля, который проведет осмотр. Если состояние оценивают как плохое, то вызывают скорую и везут в клинику», — заключила Ансталь.
- Телеграм
- Дзен
- Подписывайтесь на наши каналы и первыми узнавайте о главных новостях и важнейших событиях дня.



Войти через социальные сети: